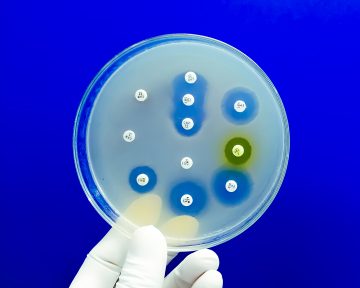

💊
 Як Prozorro Market кардинально змінив сферу медичних закупівель в Україні? Це питання стало ключовою темою для обговорення в межах форуму 19 вересня, організованого ДП «Медичні закупівлі України» (МЗУ). Захід відбувся за підтримки Агентства США з міжнародного розвитку (USAID) через проєкт «Безпечні, доступні та ефективні ліки для українців» (SAFEMed). Під час форуму було представлено результати 5-річного адміністрування МЗУ медичної частини каталогу, зокрема збільшення обсягів продажу медичних товарів до 10,1 млрд грн через електронний (е-) каталог Prozorro Market та заощадження понад 520 млн грн у 2023 р. Також на заході обговорювали виклики та можливості для подальшого розширення асортименту каталогу, а постачальники та замовники поділилися своїм досвідом використання платформи. Форум зібрав офлайн та онлайн понад 700 представників закладів охорони здоров’я зі всієї України, бізнес-асоціацій та міжнародних організацій, електронних майданчиків та центральних закупівельних організацій. 🌿
Як Prozorro Market кардинально змінив сферу медичних закупівель в Україні? Це питання стало ключовою темою для обговорення в межах форуму 19 вересня, організованого ДП «Медичні закупівлі України» (МЗУ). Захід відбувся за підтримки Агентства США з міжнародного розвитку (USAID) через проєкт «Безпечні, доступні та ефективні ліки для українців» (SAFEMed). Під час форуму було представлено результати 5-річного адміністрування МЗУ медичної частини каталогу, зокрема збільшення обсягів продажу медичних товарів до 10,1 млрд грн через електронний (е-) каталог Prozorro Market та заощадження понад 520 млн грн у 2023 р. Також на заході обговорювали виклики та можливості для подальшого розширення асортименту каталогу, а постачальники та замовники поділилися своїм досвідом використання платформи. Форум зібрав офлайн та онлайн понад 700 представників закладів охорони здоров’я зі всієї України, бізнес-асоціацій та міжнародних організацій, електронних майданчиків та центральних закупівельних організацій. 🌿📚 Читати далі: https://bit.ly/3TPFNyM
apteka.ua
📨 Приєднуйся у Telegram канал: https://bit.ly/44ixn66
📱 або Viber канал: http://bit.ly/3XCHfEc
 На сайті Благодійного фонду «Пацієнти України» повідомляється, що закладена в проєкті Державного бюджету на 2025 р. вимога щодо переведення усіх медичних закладів на казначейські рахунки фактично спричинить колапс у роботі системи охорони здоров’я і залишить мільйони пацієнтів без необхідної медичної допомоги під час війни.
На сайті Благодійного фонду «Пацієнти України» повідомляється, що закладена в проєкті Державного бюджету на 2025 р. вимога щодо переведення усіх медичних закладів на казначейські рахунки фактично спричинить колапс у роботі системи охорони здоров’я і залишить мільйони пацієнтів без необхідної медичної допомоги під час війни. Міністерство фінансів України повідомляє, що до загального фонду державного бюджету надійшли 10 млн євро пільгового фінансування від Банку Розвитку Ради Європи (БРРЄ). Це – перший транш БРРЄ на умовах спільного фінансування в межах проєкту Світового банку «Зміцнення системи охорони здоров’я та збереження життя (HEAL Ukraine)». 🌿
Міністерство фінансів України повідомляє, що до загального фонду державного бюджету надійшли 10 млн євро пільгового фінансування від Банку Розвитку Ради Європи (БРРЄ). Це – перший транш БРРЄ на умовах спільного фінансування в межах проєкту Світового банку «Зміцнення системи охорони здоров’я та збереження життя (HEAL Ukraine)». 🌿 У серпні 2024 р. Міністерством охорони здоров'я (МОЗ) України оприлюднено проєкт постанови Кабінет Міністрів України (КМУ), який передбачає внесення змін до чинних нормативних актів, що регулюють процес укладання договорів керованого доступу (ДКД). 🌿
У серпні 2024 р. Міністерством охорони здоров'я (МОЗ) України оприлюднено проєкт постанови Кабінет Міністрів України (КМУ), який передбачає внесення змін до чинних нормативних актів, що регулюють процес укладання договорів керованого доступу (ДКД). 🌿 24 вересня в інформаційному агентстві «Інтерфакс-Україна» відбулася пресконференція, під час якої представники низки організацій, що захищають права тяжкохворих пацієнтів у доступі до інноваційних ліків, озвучать свою позицію щодо юридичної колізії внаслідок рішень МОЗ, яка призвела до призупинення закупівель життєво необхідних ліків на регіональному рівні та поставила під загрозу життя і здоров’я пацієнтів із орфанними, онкологічними та іншими тяжкими захворюваннями. У заході взяли участь Віктор Сердюк, президент всеукраїнської благодійної організації «Рада захисту прав та безпеки пацієнтів», Володимир Редько, виконавчий директор громадської спілки «Асоціація виробників інноваційних ліків», Ганна Узлова, директорка та співзасновниця фонду підтримки дорослих онкопацієнтів Inspiration Family, Тетяна Кулеша, голова ради громадської спілки «Орфанні захворювання України», а також пацієнти з тяжкими захворюваннями, що потребують інноваційних ліків для продовження життєдіяльності. 🌿
24 вересня в інформаційному агентстві «Інтерфакс-Україна» відбулася пресконференція, під час якої представники низки організацій, що захищають права тяжкохворих пацієнтів у доступі до інноваційних ліків, озвучать свою позицію щодо юридичної колізії внаслідок рішень МОЗ, яка призвела до призупинення закупівель життєво необхідних ліків на регіональному рівні та поставила під загрозу життя і здоров’я пацієнтів із орфанними, онкологічними та іншими тяжкими захворюваннями. У заході взяли участь Віктор Сердюк, президент всеукраїнської благодійної організації «Рада захисту прав та безпеки пацієнтів», Володимир Редько, виконавчий директор громадської спілки «Асоціація виробників інноваційних ліків», Ганна Узлова, директорка та співзасновниця фонду підтримки дорослих онкопацієнтів Inspiration Family, Тетяна Кулеша, голова ради громадської спілки «Орфанні захворювання України», а також пацієнти з тяжкими захворюваннями, що потребують інноваційних ліків для продовження життєдіяльності. 🌿 Державна служба України з лікарських засобів та контролю за наркотиками (далі – Держлікслужба) нагадує, що згідно зі ст. 14 Закону України «Про наркотичні засоби, психотропні речовини і прекурсори» відомство розпочало підготовку проєкту постанови Кабінету Міністрів України (КМУ) «Про затвердження обсягів квот на 2025 рік, у межах яких здійснюється культивування рослин, що містять наркотичні засоби і психотропні речовини, виробництво, виготовлення, зберігання, ввезення на територію України та вивезення з території України наркотичних засобів і психотропних речовин». 🌿
Державна служба України з лікарських засобів та контролю за наркотиками (далі – Держлікслужба) нагадує, що згідно зі ст. 14 Закону України «Про наркотичні засоби, психотропні речовини і прекурсори» відомство розпочало підготовку проєкту постанови Кабінету Міністрів України (КМУ) «Про затвердження обсягів квот на 2025 рік, у межах яких здійснюється культивування рослин, що містять наркотичні засоби і психотропні речовини, виробництво, виготовлення, зберігання, ввезення на територію України та вивезення з території України наркотичних засобів і психотропних речовин». 🌿 Напередодні Всесвітнього дня фармацевта в Копенгагені, Данія, відбувся симпозіум високого рівня, організований Європейським регіональним бюро Всесвітньої організації охорони здоров’я (ВООЗ) та Міжнародною федерацією фармацевтів (International Pharmacists Federation — FIP) з приводу надання фармацевтичної опіки та фармацевтичних послуг. Під час заходу експерти обговорювали, який внесок фармацевти можуть зробити в надання пацієнтам медичної допомоги і як ці ролі вписуються в міждисциплінарний підхід до збереження здоров’я в умовах лікарень та в громадах. 🌿
Напередодні Всесвітнього дня фармацевта в Копенгагені, Данія, відбувся симпозіум високого рівня, організований Європейським регіональним бюро Всесвітньої організації охорони здоров’я (ВООЗ) та Міжнародною федерацією фармацевтів (International Pharmacists Federation — FIP) з приводу надання фармацевтичної опіки та фармацевтичних послуг. Під час заходу експерти обговорювали, який внесок фармацевти можуть зробити в надання пацієнтам медичної допомоги і як ці ролі вписуються в міждисциплінарний підхід до збереження здоров’я в умовах лікарень та в громадах. 🌿 У серпні 2024 р. обсяги аптечного продажу ліків зросли на 24% у грошовому вираженні та на 4,5% — у натуральному порівняно з аналогічним періодом минулого року. Значний внесок у зростання ринку в серпні внесла чергова хвиля COVID-19. Унаслідок цього в серпні обсяги продажу ліків суттєво збільшилися. У вересні темпи розвитку ринку суттєво сповільнилися, за період з 1 до 24 вересня зростання у грошовому вираженні становить 15%, а у натуральному фіксується спад на 3%. Наразі зберігається тенденція до сповільнення темпів зростання обсягів продажу у грошовому вираженні та поглиблення спаду у натуральному. Загалом же за 38 тиж обсяги роздрібної реалізації ліків зросли на 17% у грошовому та на 0,2% — у натуральному вираженні. Тобто зростання у грошовому вираженні відбувається переважно за рахунок інфляції, адже фізичне споживання майже не змінилося порівняно із аналогічним періодом минулого року. У цій публікації наведені обсяги продажу ліків з початку 2024 р. у потижневій та поденній динаміці. Для підготовки матеріалу використані дані аналітичної системи дослідження ринку «PharmXplorer» компанії «Proxima Research». 🌿
У серпні 2024 р. обсяги аптечного продажу ліків зросли на 24% у грошовому вираженні та на 4,5% — у натуральному порівняно з аналогічним періодом минулого року. Значний внесок у зростання ринку в серпні внесла чергова хвиля COVID-19. Унаслідок цього в серпні обсяги продажу ліків суттєво збільшилися. У вересні темпи розвитку ринку суттєво сповільнилися, за період з 1 до 24 вересня зростання у грошовому вираженні становить 15%, а у натуральному фіксується спад на 3%. Наразі зберігається тенденція до сповільнення темпів зростання обсягів продажу у грошовому вираженні та поглиблення спаду у натуральному. Загалом же за 38 тиж обсяги роздрібної реалізації ліків зросли на 17% у грошовому та на 0,2% — у натуральному вираженні. Тобто зростання у грошовому вираженні відбувається переважно за рахунок інфляції, адже фізичне споживання майже не змінилося порівняно із аналогічним періодом минулого року. У цій публікації наведені обсяги продажу ліків з початку 2024 р. у потижневій та поденній динаміці. Для підготовки матеріалу використані дані аналітичної системи дослідження ринку «PharmXplorer» компанії «Proxima Research». 🌿 Нещодавно Національна служба здоров’я України (НСЗУ) у співпраці з проєктом Агентства США з міжнародного розвитку (USAID) Ukraine «Безпечні, доступні та ефективні ліки для українців» (SAFEMed) провели форум «Реімбурсація 2024» (далі — Форум). Захід став комунікаційною платформою для обговорення поточних проблем програми реімбурсації, можливих шляхів їх розв’язання, подальшого розвитку програми та ін. Він складався з 3 панельних дискусій, які висвітлюватимуться в межах цієї публікації. Модераторкою форуму виступила Олена Філінюк, старша технічна радниця з питань фармацевтичного врядування та фінансування SAFEMed USAID Activity. У заході взяли участь, зокрема, представники Міністерства охорони здоров’я (МОЗ) України, Верховної Ради України, НСЗУ, USAID SAFEMed, Всесвітньої організації охорони здоров’я (ВООЗ), міжнародних організацій, представники виробників ліків, аптечних мереж, пацієнтських організацій тощо. 🌿
Нещодавно Національна служба здоров’я України (НСЗУ) у співпраці з проєктом Агентства США з міжнародного розвитку (USAID) Ukraine «Безпечні, доступні та ефективні ліки для українців» (SAFEMed) провели форум «Реімбурсація 2024» (далі — Форум). Захід став комунікаційною платформою для обговорення поточних проблем програми реімбурсації, можливих шляхів їх розв’язання, подальшого розвитку програми та ін. Він складався з 3 панельних дискусій, які висвітлюватимуться в межах цієї публікації. Модераторкою форуму виступила Олена Філінюк, старша технічна радниця з питань фармацевтичного врядування та фінансування SAFEMed USAID Activity. У заході взяли участь, зокрема, представники Міністерства охорони здоров’я (МОЗ) України, Верховної Ради України, НСЗУ, USAID SAFEMed, Всесвітньої організації охорони здоров’я (ВООЗ), міжнародних організацій, представники виробників ліків, аптечних мереж, пацієнтських організацій тощо. 🌿 26 вересня Уряд призначив Яблонську Лесю Леонідівну заступником Голови Державної служби України з лікарських засобів та контролю за наркотиками з питань цифрового розвитку, цифрових трансформацій і цифровізації.
26 вересня Уряд призначив Яблонську Лесю Леонідівну заступником Голови Державної служби України з лікарських засобів та контролю за наркотиками з питань цифрового розвитку, цифрових трансформацій і цифровізації. Розпорядженням Кабінету Міністрів України від 24.09.2024 р. № 900-р Державне підприємство «Медичні закупівлі України» визначено отримувачем гуманітарної допомоги на період воєнного стану та протягом 3 міс з дня його припинення чи скасування. 🌿
Розпорядженням Кабінету Міністрів України від 24.09.2024 р. № 900-р Державне підприємство «Медичні закупівлі України» визначено отримувачем гуманітарної допомоги на період воєнного стану та протягом 3 міс з дня його припинення чи скасування. 🌿 Комітет з лікарських засобів для застосування у людини (Committee for Medicinal Products for Human Use — CHMP) Європейського агентства з лікарських засобів (European Medicines Agency — EMA) на своєму засіданні у вересні 2024 р. обрав Бруно Сеподеса (Bruno Sepodes) своїм новим головою. Професор Б. Сеподес розпочав свій трирічний мандат 21 вересня, замінивши на цій посаді Харальда Енцманна (Harald Enzmann), який пропрацював два трирічних терміни – максимум, дозволений для керівників CHMP. Також ухвалено ряд рішень щодо лікарських засобів (таблиця). 🌿
Комітет з лікарських засобів для застосування у людини (Committee for Medicinal Products for Human Use — CHMP) Європейського агентства з лікарських засобів (European Medicines Agency — EMA) на своєму засіданні у вересні 2024 р. обрав Бруно Сеподеса (Bruno Sepodes) своїм новим головою. Професор Б. Сеподес розпочав свій трирічний мандат 21 вересня, замінивши на цій посаді Харальда Енцманна (Harald Enzmann), який пропрацював два трирічних терміни – максимум, дозволений для керівників CHMP. Також ухвалено ряд рішень щодо лікарських засобів (таблиця). 🌿 Управління з контролю за харчовими продуктами та лікарськими засобами (Food and Drug Administration — FDA) видало компанії «IntraBio Inc.» дозвіл на маркетинг препарата Aqneursa (левацетиллейцин) для лікування неврологічних симптомів, пов’язаних із хворобою Німана — Піка типу C (НП-C) у дорослих і дітей з масою тіла щонайменше 15 кг. 🌿
Управління з контролю за харчовими продуктами та лікарськими засобами (Food and Drug Administration — FDA) видало компанії «IntraBio Inc.» дозвіл на маркетинг препарата Aqneursa (левацетиллейцин) для лікування неврологічних симптомів, пов’язаних із хворобою Німана — Піка типу C (НП-C) у дорослих і дітей з масою тіла щонайменше 15 кг. 🌿 Державна служба України з лікарських засобів та контролю за наркотиками (Держлікслужба) звертає увагу керівників суб’єктів господарювання, які здійснюють господарську діяльність з виробництва лікарських засобів, оптової, роздрібної торгівлі лікарськими засобами на наступне. 🌿
Державна служба України з лікарських засобів та контролю за наркотиками (Держлікслужба) звертає увагу керівників суб’єктів господарювання, які здійснюють господарську діяльність з виробництва лікарських засобів, оптової, роздрібної торгівлі лікарськими засобами на наступне. 🌿 Управління з контролю за харчовими продуктами та лікарськими засобами (Food and Drug Administration — FDA) надало компанії Zevra Therapeutics дозвіл на маркетинг перорального препарату Miplyffa (аримокломол) для лікування хвороби Німана — Піка типу C (НП-C). Аримокломол у поєднанні з міглустатом (інгібітором ферменту глюкозилцерамідсинтази) схвалений для лікування неврологічних симптомів, пов’язаних з НП-C, у дорослих і дітей віком від 2 років. Аримокломол є першим препаратом, схваленим FDA для лікування НП-C. 🌿
Управління з контролю за харчовими продуктами та лікарськими засобами (Food and Drug Administration — FDA) надало компанії Zevra Therapeutics дозвіл на маркетинг перорального препарату Miplyffa (аримокломол) для лікування хвороби Німана — Піка типу C (НП-C). Аримокломол у поєднанні з міглустатом (інгібітором ферменту глюкозилцерамідсинтази) схвалений для лікування неврологічних симптомів, пов’язаних з НП-C, у дорослих і дітей віком від 2 років. Аримокломол є першим препаратом, схваленим FDA для лікування НП-C. 🌿 Стрімкий розвиток штучного інтелекту (ШІ), зокрема у сфері охорони здоров’я, має потенціал кардинально змінити лікування в майбутньому. Кількість стартапів та технологічних компаній, орієнтованих на ШІ, у Європі швидко зростає. Так, дані венчурного фонду Earlybird Venture Capital свідчать про те, що у 2023 р. в Європі налічувалося близько 1,7 тис. стартапів, орієнтованих на ШІ. Хоча з них невелика частка працює у сфері охорони здоров’я, загальна тенденція до зростання залученості ШІ, безумовно, відображається на цій галузі. У даних аналітичної компанії GlobalData зазначено, що найм працівників, пов'язаних зі ШІ, у європейському фармацевтичному та медичному секторі стрімко зростав протягом останніх 5 років, причому навіть у періоди, коли в інших галузях відмічалося затишшя. 🌿
Стрімкий розвиток штучного інтелекту (ШІ), зокрема у сфері охорони здоров’я, має потенціал кардинально змінити лікування в майбутньому. Кількість стартапів та технологічних компаній, орієнтованих на ШІ, у Європі швидко зростає. Так, дані венчурного фонду Earlybird Venture Capital свідчать про те, що у 2023 р. в Європі налічувалося близько 1,7 тис. стартапів, орієнтованих на ШІ. Хоча з них невелика частка працює у сфері охорони здоров’я, загальна тенденція до зростання залученості ШІ, безумовно, відображається на цій галузі. У даних аналітичної компанії GlobalData зазначено, що найм працівників, пов'язаних зі ШІ, у європейському фармацевтичному та медичному секторі стрімко зростав протягом останніх 5 років, причому навіть у періоди, коли в інших галузях відмічалося затишшя. 🌿 Міністерство охорони здоров’я (МОЗ) України нагадує, що з жовтня 2023 р. Національна служба здоров’я України (НСЗУ) почала відшкодовувати аптечним закладам вартість тест-смужок для встановлення рівня глюкози для індивідуальних глюкометрів. 🌿
Міністерство охорони здоров’я (МОЗ) України нагадує, що з жовтня 2023 р. Національна служба здоров’я України (НСЗУ) почала відшкодовувати аптечним закладам вартість тест-смужок для встановлення рівня глюкози для індивідуальних глюкометрів. 🌿 Нещодавно вчені виявили, що на вираженість алергічних проявів можуть впливати клітини вродженого імунітету. Проте поки теорія науковців залишається до кінця не підтвердженою, а дослідження тривають, основним «важелем» контролю алергії залишається антигістамінна терапія. Зокрема, йдеться про застосування для зменшення вираженості симптомів алергії у дітей та дорослих антигістамінного засобу 2-го покоління лоратадину. 🌿
Нещодавно вчені виявили, що на вираженість алергічних проявів можуть впливати клітини вродженого імунітету. Проте поки теорія науковців залишається до кінця не підтвердженою, а дослідження тривають, основним «важелем» контролю алергії залишається антигістамінна терапія. Зокрема, йдеться про застосування для зменшення вираженості симптомів алергії у дітей та дорослих антигістамінного засобу 2-го покоління лоратадину. 🌿 Державна служба України з лікарських засобів та контролю за наркотиками (Держлікслужба) повідомляє, що згідно з Порядком здійснення контролю за відповідністю імунобіологічних препаратів, що застосовуються в медичній практиці, вимогам державних і міжнародних стандартів, обов’язковому лабораторному аналізу за показниками специфікації якості методів контролю якості підлягають, зокрема, вакцини. 🌿
Державна служба України з лікарських засобів та контролю за наркотиками (Держлікслужба) повідомляє, що згідно з Порядком здійснення контролю за відповідністю імунобіологічних препаратів, що застосовуються в медичній практиці, вимогам державних і міжнародних стандартів, обов’язковому лабораторному аналізу за показниками специфікації якості методів контролю якості підлягають, зокрема, вакцини. 🌿 У період 1990–2021 рр. більше 1 млн випадків смерті щороку були безпосередньо пов’язані зі стійкістю до антибіотиків. Про це свідчать результати Глобального дослідження антимікробної резистентності (Global Research on Antimicrobial Resistance — GRAM), опубліковані у журналі «The Lancet» 16 вересня. 🌿
У період 1990–2021 рр. більше 1 млн випадків смерті щороку були безпосередньо пов’язані зі стійкістю до антибіотиків. Про це свідчать результати Глобального дослідження антимікробної резистентності (Global Research on Antimicrobial Resistance — GRAM), опубліковані у журналі «The Lancet» 16 вересня. 🌿 Кабінет Міністрів України під час засідання 20 вересня ухвалив рішення про внесення змін до Положення про Державну службу України з лікарських засобів та контролю за наркотиками (далі — Держлікслужба), затвердженого постановою КМУ від 12 серпня 2015 р. № 647. Наразі текст ухваленого рішення не оприлюднено. 🌿
Кабінет Міністрів України під час засідання 20 вересня ухвалив рішення про внесення змін до Положення про Державну службу України з лікарських засобів та контролю за наркотиками (далі — Держлікслужба), затвердженого постановою КМУ від 12 серпня 2015 р. № 647. Наразі текст ухваленого рішення не оприлюднено. 🌿 Останні 4 тиж фіксується сповільнення темпів зростання обсягів аптечного продажу ліків у грошовому вираженні порівняно з обсягами продажу за аналогічний період минулого року. У натуральному вираженні обсяги роздрібного продажу ліків взагалі менші за минулорічні показники. Враховуючи зниження фізичного споживання, зростання у грошовому вираженні знову відбувається за рахунок інфляційної складової. Загалом у серпні 2024 р. обсяги продажу ліків зросли на 24% у грошовому та на 4,5% — у натуральному вираженні порівняно з аналогічним періодом минулого року. У першій половині вересня темпи розвитку гірші, за період з 1 до 17 вересня зростання у грошовому вираженні становить 18%, а у натуральному фіксується спад на 1%. У цій публікації наведені обсяги продажу ліків з початку 2024 р. у потижневій та поденній динаміці. Для підготовки матеріалу використані дані аналітичної системи дослідження ринку «PharmXplorer» компанії «Proxima Research». 🌿
Останні 4 тиж фіксується сповільнення темпів зростання обсягів аптечного продажу ліків у грошовому вираженні порівняно з обсягами продажу за аналогічний період минулого року. У натуральному вираженні обсяги роздрібного продажу ліків взагалі менші за минулорічні показники. Враховуючи зниження фізичного споживання, зростання у грошовому вираженні знову відбувається за рахунок інфляційної складової. Загалом у серпні 2024 р. обсяги продажу ліків зросли на 24% у грошовому та на 4,5% — у натуральному вираженні порівняно з аналогічним періодом минулого року. У першій половині вересня темпи розвитку гірші, за період з 1 до 17 вересня зростання у грошовому вираженні становить 18%, а у натуральному фіксується спад на 1%. У цій публікації наведені обсяги продажу ліків з початку 2024 р. у потижневій та поденній динаміці. Для підготовки матеріалу використані дані аналітичної системи дослідження ринку «PharmXplorer» компанії «Proxima Research». 🌿 Кумедні, химерні, дивні і навіть божевільні — так називають відкриття, яким присуджують Антинобелівську, або Шнобелівську премію (Ig Nobel Prize) за місяць до присудження Нобелівської премії. Причому нагороди зазвичай вручають нобелівські лауреати. 34-та Церемонія вручення Шнобелівської премії «за відкриття, які змушують спочатку усміхнутися, а потім задуматися» відбулася 12 вересня 2024 р. в Массачусетському технологічному інституті у Кембриджі, США. Метою вручення таких премій є вшанування фантазії й цікавості, а також стимулювання інтересу людей до науки, медицини та технологій. Отже, на що витратили свій час, фантазію й цікавість лауреати Шнобелівської премії 2024 р.? 🌿
Кумедні, химерні, дивні і навіть божевільні — так називають відкриття, яким присуджують Антинобелівську, або Шнобелівську премію (Ig Nobel Prize) за місяць до присудження Нобелівської премії. Причому нагороди зазвичай вручають нобелівські лауреати. 34-та Церемонія вручення Шнобелівської премії «за відкриття, які змушують спочатку усміхнутися, а потім задуматися» відбулася 12 вересня 2024 р. в Массачусетському технологічному інституті у Кембриджі, США. Метою вручення таких премій є вшанування фантазії й цікавості, а також стимулювання інтересу людей до науки, медицини та технологій. Отже, на що витратили свій час, фантазію й цікавість лауреати Шнобелівської премії 2024 р.? 🌿 У серпні 2024 р. запрацював Єдиний вебпортал вакантних посад у закладах охорони здоров’я – місце, де зібрані усі вакантні посади для медичних працівників у державних та комунальних медичних закладах. Розглядається можливість з часом розміщення вакансій також приватними закладами. 🌿
У серпні 2024 р. запрацював Єдиний вебпортал вакантних посад у закладах охорони здоров’я – місце, де зібрані усі вакантні посади для медичних працівників у державних та комунальних медичних закладах. Розглядається можливість з часом розміщення вакансій також приватними закладами. 🌿 Нещодавно ДП «Медичні закупівлі України» (МЗУ) створено зручний дашборд, що дозволяє пацієнтам, постачальникам та громадськості легко отримати інформацію про статуси договорів керованого доступу (ДКД). 🌿
Нещодавно ДП «Медичні закупівлі України» (МЗУ) створено зручний дашборд, що дозволяє пацієнтам, постачальникам та громадськості легко отримати інформацію про статуси договорів керованого доступу (ДКД). 🌿 16 вересня під головуванням Михайла Радуцького відбулося чергове засідання Комітету Верховної Ради України з питань здоров’я нації, медичної допомоги та медичного страхування (далі — Комітет). Під час засідання обговорювалися такі законопроєкти: «Про внесення змін до Закону України «Про лікарські засоби» щодо особливостей державної реєстрації лікарських засобів, які можуть закуповуватися особою, уповноваженою на здійснення закупівель у сфері охорони здоров’я» (реєстр. № 11493); «Про внесення змін до деяких законодавчих актів України щодо підготовки, безперервного професійного розвитку та професійної діяльності за професіями у сфері охорони здоров’я» (реєстр. № 11527); «Про внесення змін до деяких законодавчих актів України у сфері національної безпеки і оборони щодо надання допомоги на догоспітальному етапі та здійснення цивільно-військового співробітництва» (реєстр. № 11423). Також обговорили проблеми в процесі підготовки державних установ Національної академії медичних наук (НАМН) України до їх участі в програмі медичних гарантій (ПМГ) та стан відновлення зруйнованих (пошкоджених) будівель Національної дитячої спеціалізованої лікарні «Охматдит» МОЗ України. 🌿
16 вересня під головуванням Михайла Радуцького відбулося чергове засідання Комітету Верховної Ради України з питань здоров’я нації, медичної допомоги та медичного страхування (далі — Комітет). Під час засідання обговорювалися такі законопроєкти: «Про внесення змін до Закону України «Про лікарські засоби» щодо особливостей державної реєстрації лікарських засобів, які можуть закуповуватися особою, уповноваженою на здійснення закупівель у сфері охорони здоров’я» (реєстр. № 11493); «Про внесення змін до деяких законодавчих актів України щодо підготовки, безперервного професійного розвитку та професійної діяльності за професіями у сфері охорони здоров’я» (реєстр. № 11527); «Про внесення змін до деяких законодавчих актів України у сфері національної безпеки і оборони щодо надання допомоги на догоспітальному етапі та здійснення цивільно-військового співробітництва» (реєстр. № 11423). Також обговорили проблеми в процесі підготовки державних установ Національної академії медичних наук (НАМН) України до їх участі в програмі медичних гарантій (ПМГ) та стан відновлення зруйнованих (пошкоджених) будівель Національної дитячої спеціалізованої лікарні «Охматдит» МОЗ України. 🌿 Міністерством охорони здоров’я (МОЗ) України 16 вересня оприлюднено для громадського обговорення проєкт наказу відомства, яким пропонується внести зміни до Порядку затвердження та проведення програми розширеного доступу пацієнтів до незареєстрованих лікарських засобів та програми доступу суб’єктів дослідження (пацієнтів) до досліджуваного лікарського засобу після завершення клінічного випробування (далі — Порядок), затвердженого наказом МОЗ України від 24.08.2022 р. № 1525. 🌿
Міністерством охорони здоров’я (МОЗ) України 16 вересня оприлюднено для громадського обговорення проєкт наказу відомства, яким пропонується внести зміни до Порядку затвердження та проведення програми розширеного доступу пацієнтів до незареєстрованих лікарських засобів та програми доступу суб’єктів дослідження (пацієнтів) до досліджуваного лікарського засобу після завершення клінічного випробування (далі — Порядок), затвердженого наказом МОЗ України від 24.08.2022 р. № 1525. 🌿 У виданні «Голос України» від 17.09.2024 р. № 125 оприлюднено Закон України від 21.08.2024 р. № 3910 «Про внесення змін до Закону України «Про лікарські засоби» щодо маркування лікарських засобів» (далі – Закон № 3910). 🌿
У виданні «Голос України» від 17.09.2024 р. № 125 оприлюднено Закон України від 21.08.2024 р. № 3910 «Про внесення змін до Закону України «Про лікарські засоби» щодо маркування лікарських засобів» (далі – Закон № 3910). 🌿 На жаль, часто буває, що пацієнти використовують інгалятори неправильно. У швейцарському дослідженні хворих на хронічне обструктивне захворювання легень (ХОЗЛ), опублікованому влітку 2024 р., виявлено, що 69,4% усіх пацієнтів неправильно використовували свій інгалятор. Після 3 пояснень ця частка зменшилася до 5,6%. Отримані результати свідчать, наскільки важливо проводити навчання хворих. В амбулаторній ланці особливо цінний внесок у донесення до пацієнтів інформації про правильне використання інгаляторів можуть зробити фармацевти. 🌿
На жаль, часто буває, що пацієнти використовують інгалятори неправильно. У швейцарському дослідженні хворих на хронічне обструктивне захворювання легень (ХОЗЛ), опублікованому влітку 2024 р., виявлено, що 69,4% усіх пацієнтів неправильно використовували свій інгалятор. Після 3 пояснень ця частка зменшилася до 5,6%. Отримані результати свідчать, наскільки важливо проводити навчання хворих. В амбулаторній ланці особливо цінний внесок у донесення до пацієнтів інформації про правильне використання інгаляторів можуть зробити фармацевти. 🌿 У серпні 2024 р. ринок продовжив активний розвиток. Обсяги аптечного продажу товарів «аптечного кошика» збільшилися як у грошовому, так і в натуральному вираженні. У грошовому вираженні темпи зростання становили 24% порівняно із серпнем 2023 р. У натуральному вираженні споживання підвищилося на 4%. Зростання в доларовому еквіваленті — 10%. Серед топ-10 груп АТС-класифікації 2-го рівня для більшості з них темпи зростання обсягів продажу в грошовому вираженні вищі за середньоринковий показник. Найвищі темпи зростання фіксуються для анальгетиків, назальних препаратів та антибіотиків. Також суттєво зросло споживання антидіабетичних препаратів. Основний внесок у розвиток ринку роблять інфляційна складова та індекс заміщення, зокрема і за рахунок збільшення фізичного споживання. Категорія дієтичних добавок продовжує зростати більш високими темпами, ніж інші категорії. Їх частка у загальній структурі ринку у серпні 2024 р. сягнула 10,7%. У цій публікації до уваги читачів представлені ключові показники фармринку України (території, підконтрольної українському уряду) у серпні 2024 р. При підготовці матеріалу використані дані аналітичної системи дослідження ринку «PharmXplorer» компанії «Proxima Research». 🌿
У серпні 2024 р. ринок продовжив активний розвиток. Обсяги аптечного продажу товарів «аптечного кошика» збільшилися як у грошовому, так і в натуральному вираженні. У грошовому вираженні темпи зростання становили 24% порівняно із серпнем 2023 р. У натуральному вираженні споживання підвищилося на 4%. Зростання в доларовому еквіваленті — 10%. Серед топ-10 груп АТС-класифікації 2-го рівня для більшості з них темпи зростання обсягів продажу в грошовому вираженні вищі за середньоринковий показник. Найвищі темпи зростання фіксуються для анальгетиків, назальних препаратів та антибіотиків. Також суттєво зросло споживання антидіабетичних препаратів. Основний внесок у розвиток ринку роблять інфляційна складова та індекс заміщення, зокрема і за рахунок збільшення фізичного споживання. Категорія дієтичних добавок продовжує зростати більш високими темпами, ніж інші категорії. Їх частка у загальній структурі ринку у серпні 2024 р. сягнула 10,7%. У цій публікації до уваги читачів представлені ключові показники фармринку України (території, підконтрольної українському уряду) у серпні 2024 р. При підготовці матеріалу використані дані аналітичної системи дослідження ринку «PharmXplorer» компанії «Proxima Research». 🌿 Днями у столиці відбулася церемонія нагородження переможців Всеукраїнської GR-премії 2024. «Премія є унікальною можливістю для GR-фахівців представити свої кейси та продемонструвати інноваційні підходи в лобіюванні. Метою премії є визнання видатних досягнень у галузі громадських відносин, що сприяють розвитку прозорої взаємодії між бізнесом і державою», — відзначають організатори події. Кожен кейс оцінювався незалежними експертами з міжнародним досвідом, зокрема фахівцями зі США. 🌿
Днями у столиці відбулася церемонія нагородження переможців Всеукраїнської GR-премії 2024. «Премія є унікальною можливістю для GR-фахівців представити свої кейси та продемонструвати інноваційні підходи в лобіюванні. Метою премії є визнання видатних досягнень у галузі громадських відносин, що сприяють розвитку прозорої взаємодії між бізнесом і державою», — відзначають організатори події. Кожен кейс оцінювався незалежними експертами з міжнародним досвідом, зокрема фахівцями зі США. 🌿 Міністерством охорони здоров’я (МОЗ) України 11 вересня оприлюднено для громадського обговорення проєкт наказу відомства «Про затвердження Змін до Порядку проведення експертизи реєстраційних матеріалів на лікарські засоби, що подаються на державну реєстрацію (перереєстрацію), а також експертизи матеріалів про внесення змін до реєстраційних матеріалів протягом дії реєстраційного посвідчення» (далі – Порядок). 🌿
Міністерством охорони здоров’я (МОЗ) України 11 вересня оприлюднено для громадського обговорення проєкт наказу відомства «Про затвердження Змін до Порядку проведення експертизи реєстраційних матеріалів на лікарські засоби, що подаються на державну реєстрацію (перереєстрацію), а також експертизи матеріалів про внесення змін до реєстраційних матеріалів протягом дії реєстраційного посвідчення» (далі – Порядок). 🌿 Правильне харчування відіграє важливу роль у житті людини та сприяє потужній підтримці її здоров’я. Що й недарма, адже їжа — це джерело поживних речовин, потрібних для росту, розвитку та повсякденної активності, тим більше у випадку, коли організм людини не може їх самостійно синтезувати. Чільне місце в переліку важливих продуктів займають ті, що містять в своєму складі жири, зокрема поліненасичені жирні омега-3 кислоти. 🌿
Правильне харчування відіграє важливу роль у житті людини та сприяє потужній підтримці її здоров’я. Що й недарма, адже їжа — це джерело поживних речовин, потрібних для росту, розвитку та повсякденної активності, тим більше у випадку, коли організм людини не може їх самостійно синтезувати. Чільне місце в переліку важливих продуктів займають ті, що містять в своєму складі жири, зокрема поліненасичені жирні омега-3 кислоти. 🌿 Міністерство охорони здоров’я України 10 вересня оприлюднило для громадського обговорення проєкт наказу відомства, яким пропонується затвердити Порядок проведення доклінічних досліджень лікарських засобів. 🌿
Міністерство охорони здоров’я України 10 вересня оприлюднило для громадського обговорення проєкт наказу відомства, яким пропонується затвердити Порядок проведення доклінічних досліджень лікарських засобів. 🌿 Міжнародна фармацевтична федерація (International Pharmaceutical Federation — FIP) оновила заяву щодо політики підвищення доступності до якісних основних лікарських засобів зі сприятливим профілем безпеки та медичних виробів для населення. У ній запропоновано низку рекомендацій стосовно вкладу, який можуть здійснити різні групи стейкхолдерів – уряд, пацієнтські організації, фармацевтична індустрія та фармацевти. 🌿
Міжнародна фармацевтична федерація (International Pharmaceutical Federation — FIP) оновила заяву щодо політики підвищення доступності до якісних основних лікарських засобів зі сприятливим профілем безпеки та медичних виробів для населення. У ній запропоновано низку рекомендацій стосовно вкладу, який можуть здійснити різні групи стейкхолдерів – уряд, пацієнтські організації, фармацевтична індустрія та фармацевти. 🌿 Кабінет Міністрів України (КМУ) ухвалив постанову, яка врегульовує механізм відбору зразків рослин роду коноплі з метою проведення лабораторних випробувань для встановлення концентрації вмісту наркотичної речовини — тетрагідроканнабінолу (ТГК). Наразі тексту ухваленої постанови не оприлюднено. 🌿
Кабінет Міністрів України (КМУ) ухвалив постанову, яка врегульовує механізм відбору зразків рослин роду коноплі з метою проведення лабораторних випробувань для встановлення концентрації вмісту наркотичної речовини — тетрагідроканнабінолу (ТГК). Наразі тексту ухваленої постанови не оприлюднено. 🌿 В Україні діє Порядок тимчасового зупинення експорту препаратів крові, вироблених із заготовленої на території України плазми крові для фракціонування, затверджений постановою Кабінету міністрів України від 15.09.2021 р. № 961. Серед іншого він встановлює, що виробник препаратів крові має право здійснювати експорт препаратів крові в період воєнного стану за умови підтвердженої наявності незнижувального запасу препаратів крові. 🌿
В Україні діє Порядок тимчасового зупинення експорту препаратів крові, вироблених із заготовленої на території України плазми крові для фракціонування, затверджений постановою Кабінету міністрів України від 15.09.2021 р. № 961. Серед іншого він встановлює, що виробник препаратів крові має право здійснювати експорт препаратів крові в період воєнного стану за умови підтвердженої наявності незнижувального запасу препаратів крові. 🌿 Через виклики, пов’язані зі старіючим суспільством, Організація Об’єднаних Націй (ООН) оголосила 2021–2030 рр. десятиріччями здорового старіння і закликала активізувати зусилля для розробки заходів медичного та соціального характеру. Зокрема, фундаментальні та клінічні дослідження можуть сприяти відкриттю діючих речовин, які зумовлюють здорове старіння. 🌿
Через виклики, пов’язані зі старіючим суспільством, Організація Об’єднаних Націй (ООН) оголосила 2021–2030 рр. десятиріччями здорового старіння і закликала активізувати зусилля для розробки заходів медичного та соціального характеру. Зокрема, фундаментальні та клінічні дослідження можуть сприяти відкриттю діючих речовин, які зумовлюють здорове старіння. 🌿 Поширення онкологічних захворювань, нові хвороби (наприклад COVID-19 чи мавпяча віспа), резистентність до низки груп лікарських засобів, зниження чутливості до використовуваної терапії — проблеми, з якими стикається сучасна людина, які потребують у багатьох випадках ухвалення термінових рішень. Зокрема, для забезпечення потреб населення необхідні нові препарати, які б могли допомогти в боротьбі із сьогоднішніми викликами. Але у людства немає часу чекати, адже процес розробки нових ліків — доволі тривалий. Встановлено, що середній час від початку першого дослідження застосування лікарського засобу у людей до отримання дозволу на його продаж становить близько 7 років (Möhrle J.J., 2024). Одним з варіантів допомоги, що може нівелювати часові обмеження, є репозиціонування препаратів. 🌿
Поширення онкологічних захворювань, нові хвороби (наприклад COVID-19 чи мавпяча віспа), резистентність до низки груп лікарських засобів, зниження чутливості до використовуваної терапії — проблеми, з якими стикається сучасна людина, які потребують у багатьох випадках ухвалення термінових рішень. Зокрема, для забезпечення потреб населення необхідні нові препарати, які б могли допомогти в боротьбі із сьогоднішніми викликами. Але у людства немає часу чекати, адже процес розробки нових ліків — доволі тривалий. Встановлено, що середній час від початку першого дослідження застосування лікарського засобу у людей до отримання дозволу на його продаж становить близько 7 років (Möhrle J.J., 2024). Одним з варіантів допомоги, що може нівелювати часові обмеження, є репозиціонування препаратів. 🌿 Підкомітет клінічних випробувань Комітету з охорони здоров’я (далі — Підкомітет) Європейської Бізнес Асоціації (European Business Association — EBA) вдруге під час дії воєнного стану провів оцінку поточного стану сфери клінічних випробувань в Україні та результатів її роботи. Цей аналіз головним чином присвячений оцінці подальшого розвитку клінічних випробувань та оновленню інформації про поточний стан і тенденції, що відмічаються в галузі. 🌿
Підкомітет клінічних випробувань Комітету з охорони здоров’я (далі — Підкомітет) Європейської Бізнес Асоціації (European Business Association — EBA) вдруге під час дії воєнного стану провів оцінку поточного стану сфери клінічних випробувань в Україні та результатів її роботи. Цей аналіз головним чином присвячений оцінці подальшого розвитку клінічних випробувань та оновленню інформації про поточний стан і тенденції, що відмічаються в галузі. 🌿 На виконання Закону України від 21 грудня 2023 р. № 3528-IX щодо легалізації медичного канабісу 25 липня Уряд ухвалив постанову № 857 «Про затвердження Положення про електронну інформаційну систему обліку вирощених рослин конопель для медичних цілей, переміщення таких рослин, продуктів їх переробки, рослинної субстанції канабісу, вироблених (виготовлених) із них лікарських засобів на всіх етапах обігу та порядок її функціонування». Документ передбачає, що усі операції з медичним канабісом — від посадки насінини, виготовлення лікарського засобу і до відпуску, суворо контролюватимуться і фіксуватимуться в електронній інформаційній системі обліку. Питання впровадження електронної інформаційної системи обліку обігу медичного канабісу (далі — Інформаційна система) стало ключовим питанням онлайн-зустрічі Міністерства охорони здоров’я (МОЗ) з операторами ринку, яка відбулася 5 вересня. 🌿
На виконання Закону України від 21 грудня 2023 р. № 3528-IX щодо легалізації медичного канабісу 25 липня Уряд ухвалив постанову № 857 «Про затвердження Положення про електронну інформаційну систему обліку вирощених рослин конопель для медичних цілей, переміщення таких рослин, продуктів їх переробки, рослинної субстанції канабісу, вироблених (виготовлених) із них лікарських засобів на всіх етапах обігу та порядок її функціонування». Документ передбачає, що усі операції з медичним канабісом — від посадки насінини, виготовлення лікарського засобу і до відпуску, суворо контролюватимуться і фіксуватимуться в електронній інформаційній системі обліку. Питання впровадження електронної інформаційної системи обліку обігу медичного канабісу (далі — Інформаційна система) стало ключовим питанням онлайн-зустрічі Міністерства охорони здоров’я (МОЗ) з операторами ринку, яка відбулася 5 вересня. 🌿 Затяжна війна вносить істотні зміни у функціонування економічної системи України загалом та ринку праці зокрема. На тлі бойових дій, відключень електроенергії, масштабного переміщення населення як усередині країни, так і за кордон, а також мобілізації у сфері зайнятості панують численні виклики. Так, хоча за кількістю пропозицій роботи ринок праці відновився, ключовим трендом залишається дефіцит кадрів. У цій публікації пропонуємо розглянути актуальні тенденції на ринку праці, зокрема щодо медиків і фармацевтів. 🌿
Затяжна війна вносить істотні зміни у функціонування економічної системи України загалом та ринку праці зокрема. На тлі бойових дій, відключень електроенергії, масштабного переміщення населення як усередині країни, так і за кордон, а також мобілізації у сфері зайнятості панують численні виклики. Так, хоча за кількістю пропозицій роботи ринок праці відновився, ключовим трендом залишається дефіцит кадрів. У цій публікації пропонуємо розглянути актуальні тенденції на ринку праці, зокрема щодо медиків і фармацевтів. 🌿 Кабінет Міністрів України постановою від 06.09.2024 р. № 1024 уніфіковує порядок атестації студентів, що здобувають фахову передвищу та вищу освіту бакалаврського та магістерського рівнів за спеціальностями галузі знань «22 Охорона здоров’я», у формі єдиного державного кваліфікаційного іспиту (ЄДКІ). Постанова № 1024 набула чинності у зв’язку із оприлюдненням в газеті «Урядовий кур’єр» від 07.09.2024 р. № 182. 🌿
Кабінет Міністрів України постановою від 06.09.2024 р. № 1024 уніфіковує порядок атестації студентів, що здобувають фахову передвищу та вищу освіту бакалаврського та магістерського рівнів за спеціальностями галузі знань «22 Охорона здоров’я», у формі єдиного державного кваліфікаційного іспиту (ЄДКІ). Постанова № 1024 набула чинності у зв’язку із оприлюдненням в газеті «Урядовий кур’єр» від 07.09.2024 р. № 182. 🌿 Про це повідомили у пресслужбі Чернівецької митниці. Громадянка України, яка поверталася з Румунії, прибула в пункт пропуску «Порубне — Сірет». Обравши для проходження митного контролю смугу «зеленого коридору», жінка заявила, що не переміщує через кордон товари, які підлягають декларуванню або обмежені до ввезення в Україну. 🌿
Про це повідомили у пресслужбі Чернівецької митниці. Громадянка України, яка поверталася з Румунії, прибула в пункт пропуску «Порубне — Сірет». Обравши для проходження митного контролю смугу «зеленого коридору», жінка заявила, що не переміщує через кордон товари, які підлягають декларуванню або обмежені до ввезення в Україну. 🌿 Комітет з оцінки ризиків у сфері фармаконагляду (Pharmacovigilance Risk Assessment Committee — PRAC) Європейського агентства з лікарських засобів (European Medicines Agency — EMA) рекомендував заходи для мінімізації серйозних наслідків агранулоцитозу, відомого побічного ефекту, спричиненого метамізолом. 🌿
Комітет з оцінки ризиків у сфері фармаконагляду (Pharmacovigilance Risk Assessment Committee — PRAC) Європейського агентства з лікарських засобів (European Medicines Agency — EMA) рекомендував заходи для мінімізації серйозних наслідків агранулоцитозу, відомого побічного ефекту, спричиненого метамізолом. 🌿 Останніми тижнями фіксувалося збільшення обсягів аптечного продажу ліків, однак в останній тиждень серпня вони знизилися порівняно з попередніми тижнями. Також сповільнилися і темпи зростання відносно обсягів за аналогічний період минулого року. Втім обсяги продажу продовжують зростати як у грошовому вираженні, так і в упаковках. Загалом за період з 1 до 31 серпня 2024 р. обсяги продажу ліків зросли на 24% у грошовому вираженні та на 5% — у натуральному порівняно з аналогічним періодом минулого року. На початку вересня ринок також продовжує зростати. У цій публікації наведені обсяги продажу ліків з початку 2024 р. у потижневій та поденній динаміці. Для підготовки матеріалу використані дані аналітичної системи дослідження ринку «PharmXplorer» компанії «Proxima Research». 🌿
Останніми тижнями фіксувалося збільшення обсягів аптечного продажу ліків, однак в останній тиждень серпня вони знизилися порівняно з попередніми тижнями. Також сповільнилися і темпи зростання відносно обсягів за аналогічний період минулого року. Втім обсяги продажу продовжують зростати як у грошовому вираженні, так і в упаковках. Загалом за період з 1 до 31 серпня 2024 р. обсяги продажу ліків зросли на 24% у грошовому вираженні та на 5% — у натуральному порівняно з аналогічним періодом минулого року. На початку вересня ринок також продовжує зростати. У цій публікації наведені обсяги продажу ліків з початку 2024 р. у потижневій та поденній динаміці. Для підготовки матеріалу використані дані аналітичної системи дослідження ринку «PharmXplorer» компанії «Proxima Research». 🌿 Зміни вносяться з метою розширення можливостей працівників сфери охорони при виборі заходів безперервного професійного розвитку (БПР), а також для покращення якості цих заходів за рахунок допуску до діяльності в якості провайдерів заходів БПР учасників проєктів міжнародної технічної допомоги. 🌿
Зміни вносяться з метою розширення можливостей працівників сфери охорони при виборі заходів безперервного професійного розвитку (БПР), а також для покращення якості цих заходів за рахунок допуску до діяльності в якості провайдерів заходів БПР учасників проєктів міжнародної технічної допомоги. 🌿 Міністерство охорони здоров’я (МОЗ) України наказом від 04.09.2024 р. № 1540 утворило робочу групу з проведення приймальних випробувань програмного забезпечення «Електронна інформаційна система обліку вирощених рослин конопель для медичних цілей, переміщення таких рослин, продуктів їх переробки, рослинної субстанції канабісу, вироблених (виготовлених) із них лікарських засобів на всіх етапах обігу» (далі — Робоча група), а також затвердило Положення про її роботу та персональний склад. 🌿
Міністерство охорони здоров’я (МОЗ) України наказом від 04.09.2024 р. № 1540 утворило робочу групу з проведення приймальних випробувань програмного забезпечення «Електронна інформаційна система обліку вирощених рослин конопель для медичних цілей, переміщення таких рослин, продуктів їх переробки, рослинної субстанції канабісу, вироблених (виготовлених) із них лікарських засобів на всіх етапах обігу» (далі — Робоча група), а також затвердило Положення про її роботу та персональний склад. 🌿 Наприкінці серпня відбувся 13-й Український форум операторів ринку медичних виробів®, який щороку виступає професійною бізнес-платформою для обговорення нагальних регуляторних питань у сфері обігу медичних виробів. Організаторами заходу виступила Асоціація «Оператори ринку медичних виробів»® AMOMD® (далі — Асоціація AMOMD®) за спонсорської підтримки компанії «Cratia». Партнери форуму — компанії «PHARMAGATE», «Uni-Cert», юридична фірма (ЮФ) «ОМП». Аналітичним партнером заходу виступила компанія «Проксіма Рісерч Інтернешнл». Інформаційні партнери — «Щотижневик АПТЕКА», LA Law Firm, Перший незалежний фармацевтичний бізнес-портал, 33-тя Міжнародна медична виставка PUBLIC HEALTH 2024, інформаційне агентство «Інтерфакс-Україна», ТОВ «ВИРОБНИЧА КОМПАНІЯ ЗДОРОВО», «MedQuality». Модерували захід Павло Харчик, президент Асоціації AMOMD®, директор ТОВ «Калина медична виробнича компанія», та Дар’я Бондаренко, виконавча директорка Асоціації AMOMD®. У цій публікації будуть висвітлені такі питання, як аналітичний огляд ринку медичних виробів, косметичної продукції, дезінфекційних засобів та дієтичних добавок; реімбурсація медичних виробів; мобілізація та бронювання співробітників та інше. 🌿
Наприкінці серпня відбувся 13-й Український форум операторів ринку медичних виробів®, який щороку виступає професійною бізнес-платформою для обговорення нагальних регуляторних питань у сфері обігу медичних виробів. Організаторами заходу виступила Асоціація «Оператори ринку медичних виробів»® AMOMD® (далі — Асоціація AMOMD®) за спонсорської підтримки компанії «Cratia». Партнери форуму — компанії «PHARMAGATE», «Uni-Cert», юридична фірма (ЮФ) «ОМП». Аналітичним партнером заходу виступила компанія «Проксіма Рісерч Інтернешнл». Інформаційні партнери — «Щотижневик АПТЕКА», LA Law Firm, Перший незалежний фармацевтичний бізнес-портал, 33-тя Міжнародна медична виставка PUBLIC HEALTH 2024, інформаційне агентство «Інтерфакс-Україна», ТОВ «ВИРОБНИЧА КОМПАНІЯ ЗДОРОВО», «MedQuality». Модерували захід Павло Харчик, президент Асоціації AMOMD®, директор ТОВ «Калина медична виробнича компанія», та Дар’я Бондаренко, виконавча директорка Асоціації AMOMD®. У цій публікації будуть висвітлені такі питання, як аналітичний огляд ринку медичних виробів, косметичної продукції, дезінфекційних засобів та дієтичних добавок; реімбурсація медичних виробів; мобілізація та бронювання співробітників та інше. 🌿 У 2024 р. Україна продовжила адаптацію свого законодавства до європейських стандартів, зокрема в сфері регулювання косметичної та хімічної продукції: ухвалено 6 нових законодавчих актів, і ще декілька знаходяться в стані розробки або обговорення. Нові технічні регламенти, розроблені на основі відповідних нормативних актів Європейського Союзу, суттєво змінюють вимоги до безпеки продуктів, що використовуються щодня мільйонами споживачів. Введення в дію Технічного регламенту на косметичну продукцію та відповідні зміни в законодавстві щодо хімічних речовин мають на меті підвищити стандарти якості, безпеки та відповідальності серед учасників ринку. У цьому контексті особливу увагу привертає питання контролю за використанням хімічних речовин та забезпечення екологічної безпеки продукції. У цій статті ми надаємо стислий огляд нових законодавчих актів та аналізуємо ключові аспекти їх впливу на ринок косметичної продукції України. 🌿
У 2024 р. Україна продовжила адаптацію свого законодавства до європейських стандартів, зокрема в сфері регулювання косметичної та хімічної продукції: ухвалено 6 нових законодавчих актів, і ще декілька знаходяться в стані розробки або обговорення. Нові технічні регламенти, розроблені на основі відповідних нормативних актів Європейського Союзу, суттєво змінюють вимоги до безпеки продуктів, що використовуються щодня мільйонами споживачів. Введення в дію Технічного регламенту на косметичну продукцію та відповідні зміни в законодавстві щодо хімічних речовин мають на меті підвищити стандарти якості, безпеки та відповідальності серед учасників ринку. У цьому контексті особливу увагу привертає питання контролю за використанням хімічних речовин та забезпечення екологічної безпеки продукції. У цій статті ми надаємо стислий огляд нових законодавчих актів та аналізуємо ключові аспекти їх впливу на ринок косметичної продукції України. 🌿